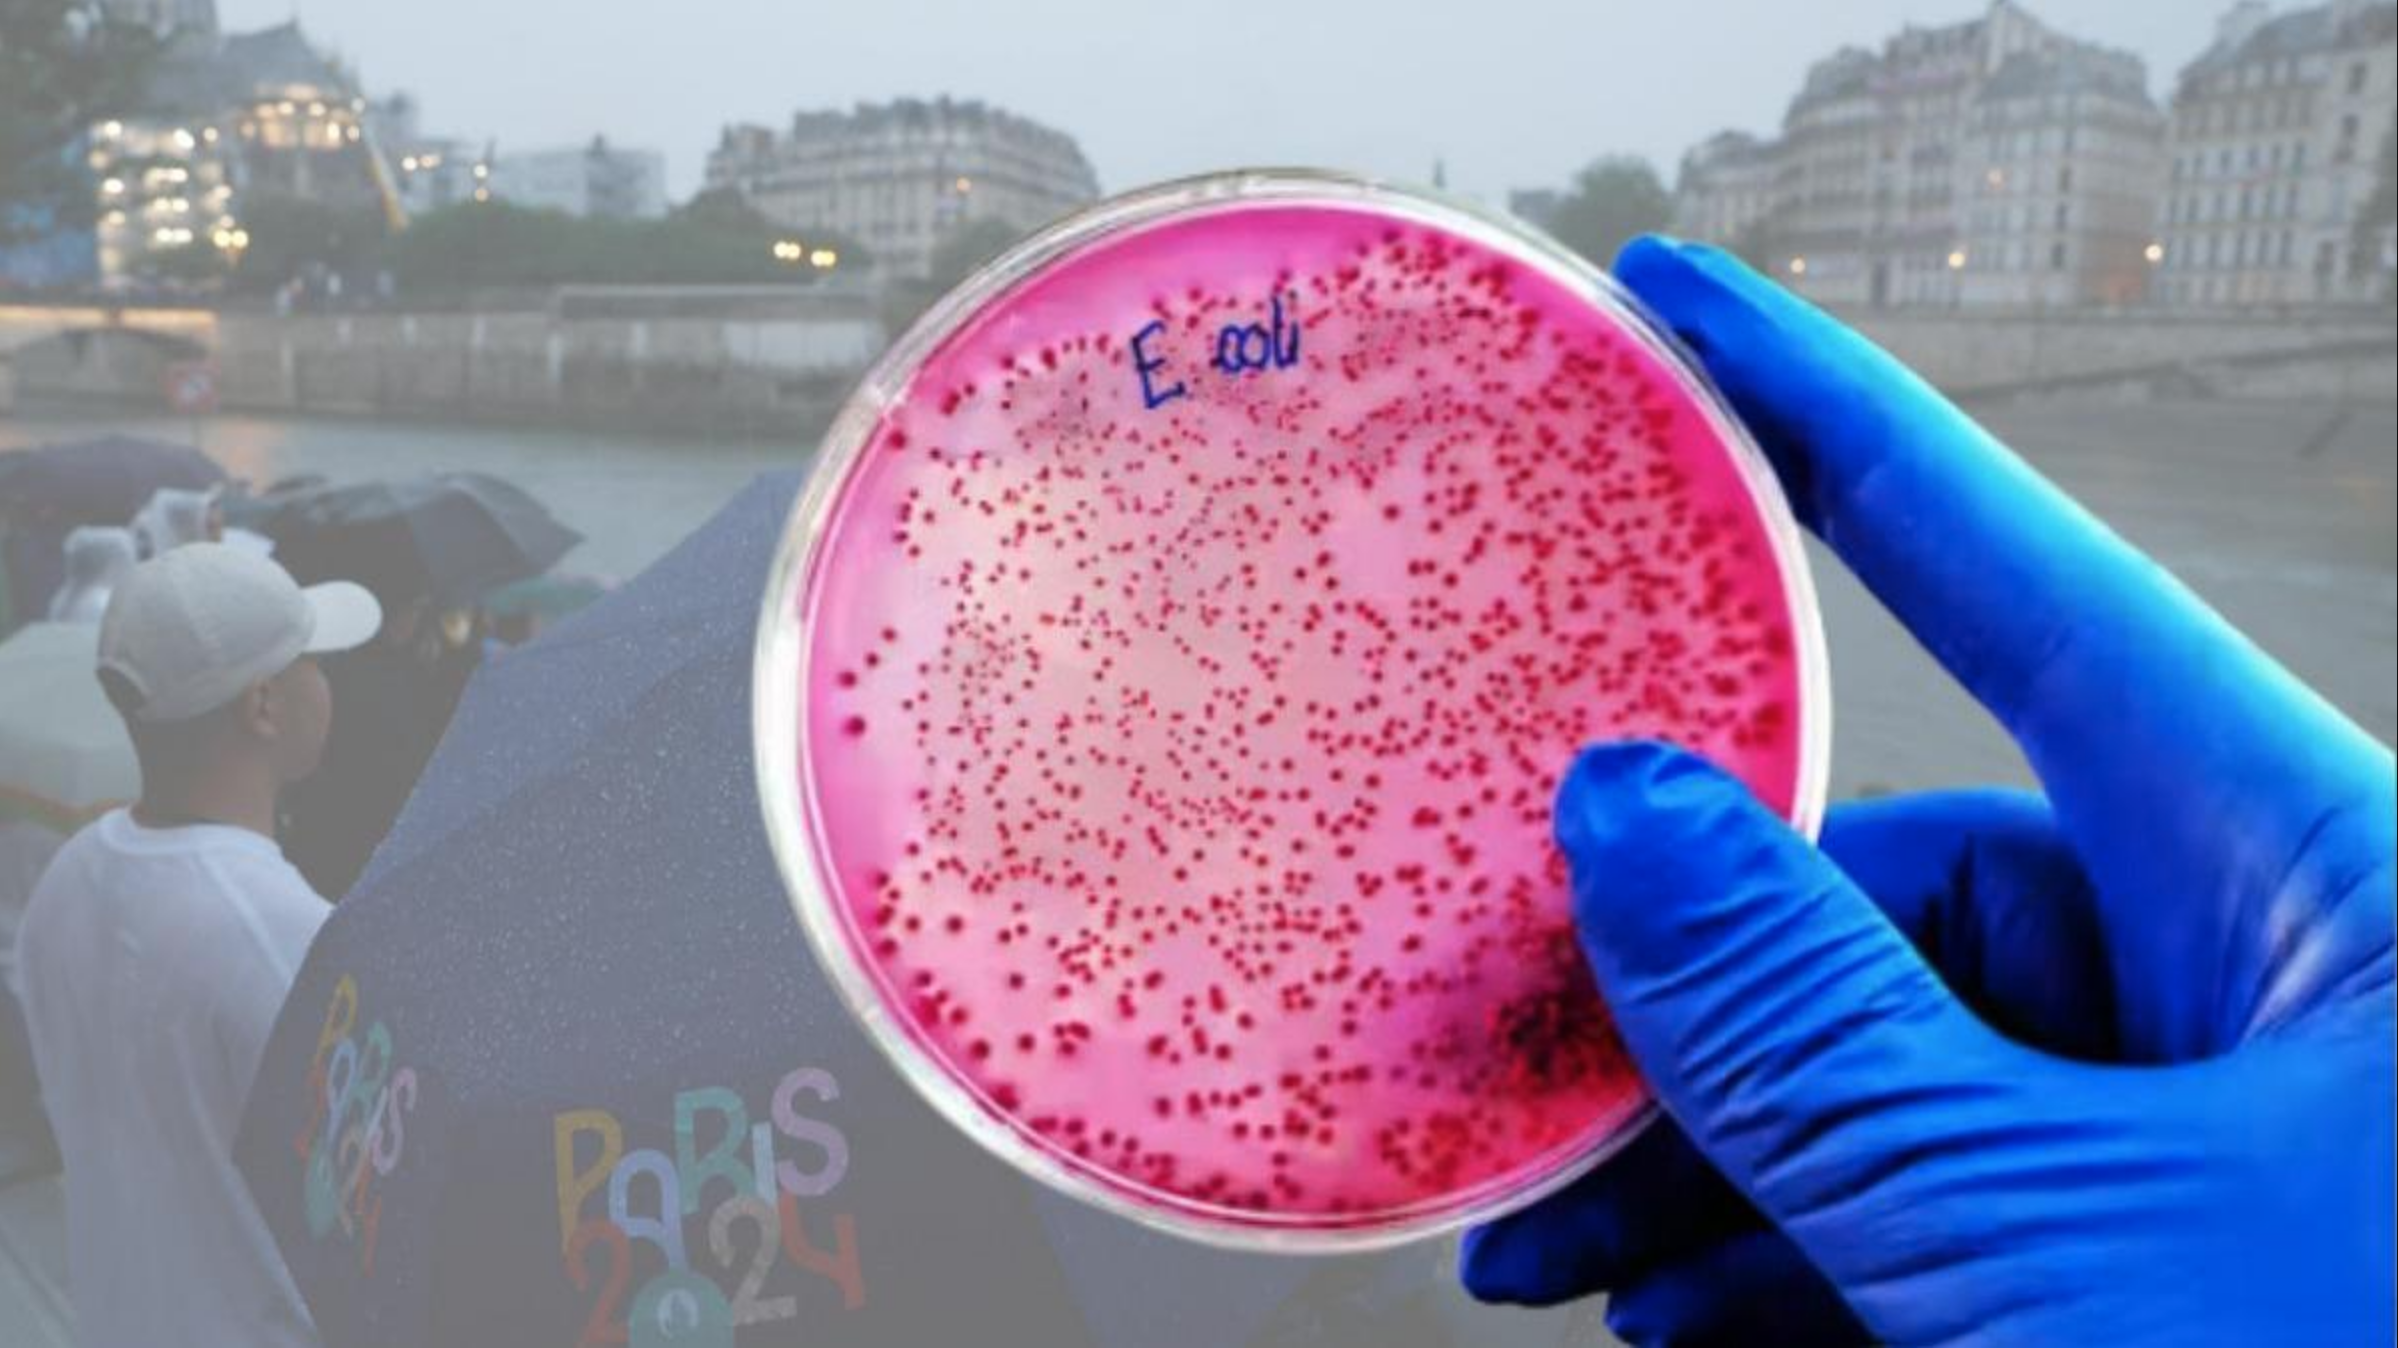

Una infección por Escherichia Coli (E. Coli) ha sido el motivo de la retirada del equipo olímpico belga de triatlón mixto de los Juegos Olímpicos 2024 en París, tras enfermar una de sus atletas debido a la calidad del agua del Río Sena.
El 4 de agosto, Claire Michel, miembro del equipo Belgian Hammers, presentó síntomas de infección por E. Coli, según informó el diario belga De Standaard.
Debido a su estado de salud, el equipo decidió retirarse de las competencias de relevos mixtos de triatlón programadas para el 5 de agosto.
Ni el equipo ni el Comité Olímpico han identificado la causa exacta de la infección, pero la calidad del agua del Río Sena ha sido un tema recurrente durante estos juegos.
El Comité Olímpico e Interfederal Belga (BOIC) expresó su deseo de aprender de esta experiencia para futuras competiciones. A lo largo de los Juegos Olímpicos, los triatletas han enfrentado múltiples ajustes debido a la contaminación del Sena, con entrenamientos aplazados y competencias postergadas.
El agua del Río Sena ha sido señalada como inadecuada para nadar debido a la alta presencia de bacterias, exacerbada por las lluvias recientes.
El sistema de alcantarillado de París, que combina aguas pluviales con residuales, provoca que las aguas negras se desborden en el río, aumentando los contaminantes de origen fecal como E. Coli.
¿Qué es la E. Coli?
La E. Coli es una bacteria que vive en el tracto gastrointestinal de humanos y animales. Aunque generalmente inofensiva, ciertas cepas pueden causar diarrea, calambres estomacales, náuseas y vómitos.
Los síntomas suelen aparecer de tres a cuatro días después de la exposición. Los principales focos de infección incluyen agua contaminada y alimentos mal preparados.
El 5 de agosto, la competencia de triatlón mixto se realizó sin la participación del equipo belga. A pesar de las preocupaciones, los organizadores aseguraron que la calidad del agua había mejorado, permitiendo la continuación del evento según lo programado.
También lee:
¿Qué Es Redotex Y Por Qué Cofepris Prohibió Su Venta?
Google Drive estrena función para transcribir automáticamente